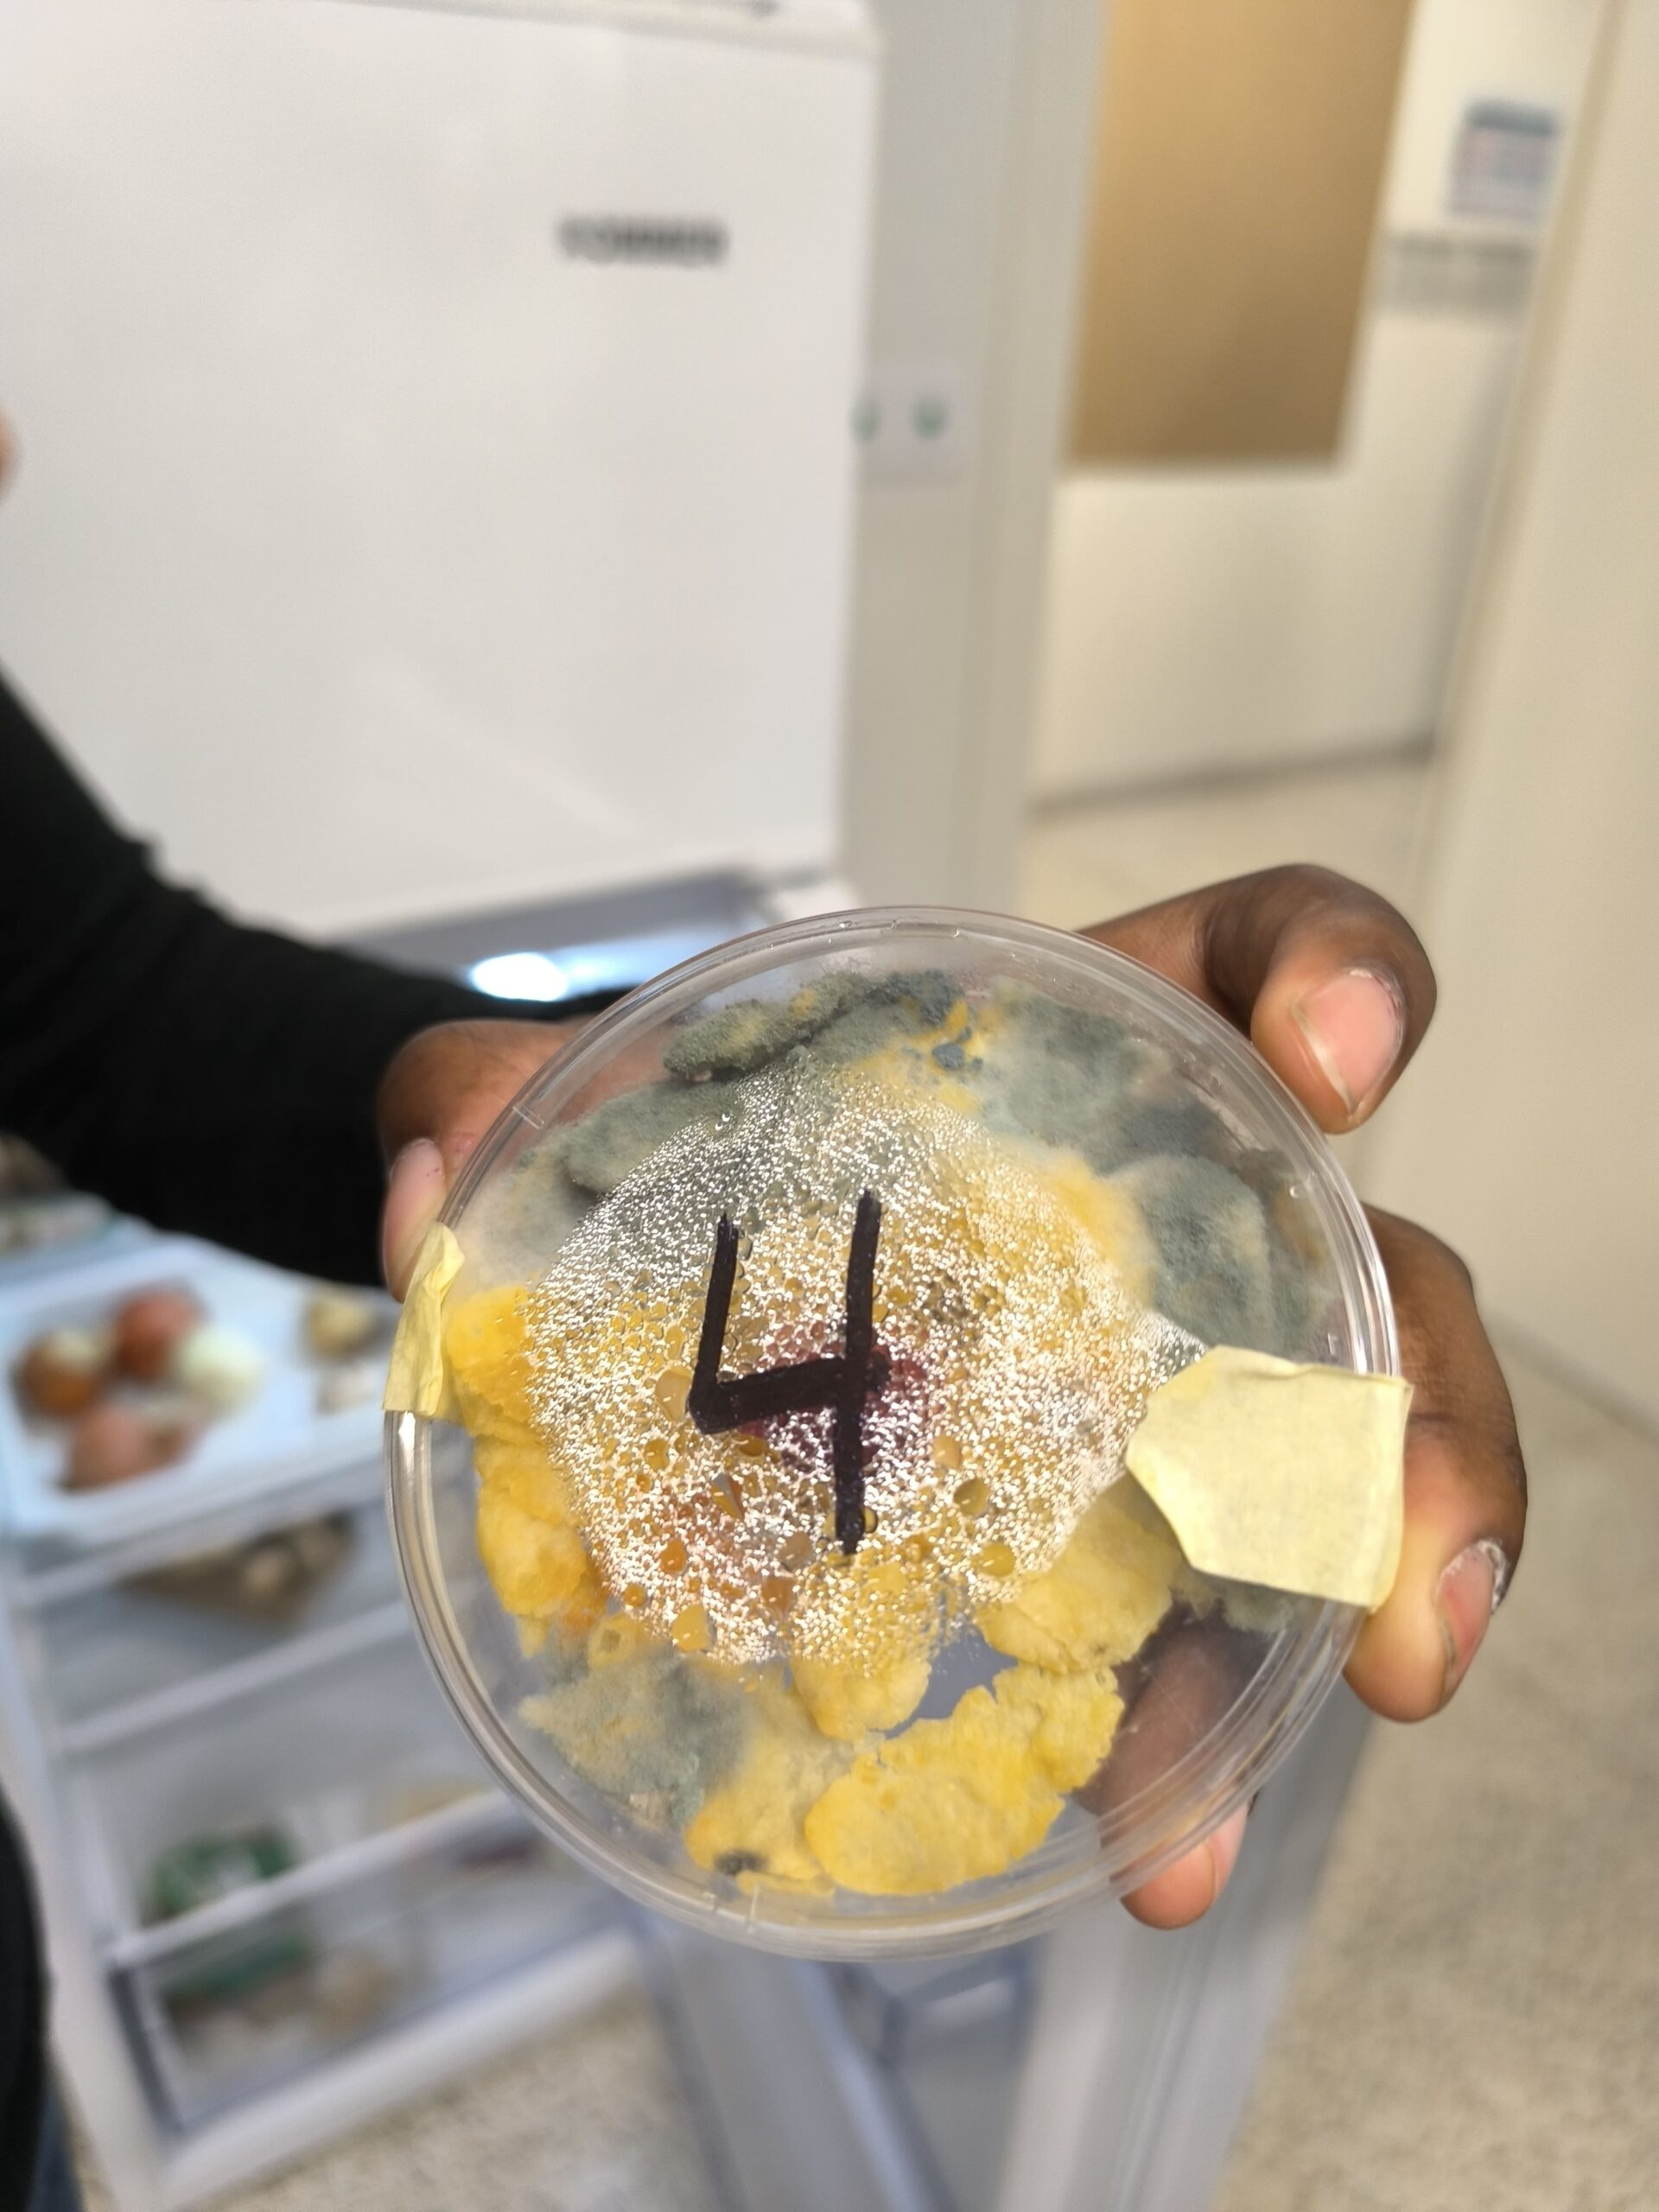
1738161445498

Tot i ja ser centre STEAM, el passat dimecres vam visitar l’institut Angeleta Ferrer de Barcelona. Institut de nova creació i centrat en metodologia Steam.
Ens van ensenyar i explicar de la mà de l’alumnat com s’organitzen, què estudien, els itineraris que tenen… tot des d’un vessant molt lliure i autònoma.
Continuem endavant formar-nos i creant xarxa.